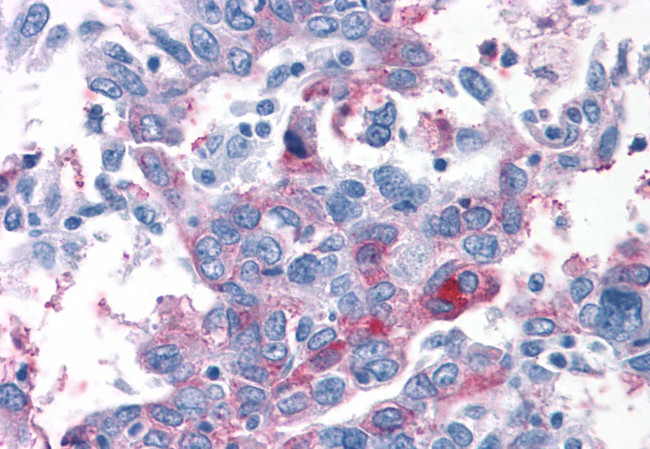
TAS1R1 Antibody in Immunohistochemistry (Paraffin) (IHC (P))

Search
Invitrogen
TAS1R1 Polyclonal Antibody
{{$productOrderCtrl.translations['antibody.pdp.commerceCard.promotion.promotions']}}
{{$productOrderCtrl.translations['antibody.pdp.commerceCard.promotion.viewpromo']}}
{{$productOrderCtrl.translations['antibody.pdp.commerceCard.promotion.promocode']}}: {{promo.promoCode}} {{promo.promoTitle}} {{promo.promoDescription}}. {{$productOrderCtrl.translations['antibody.pdp.commerceCard.promotion.learnmore']}}
产品信息
PA5-34252
种属反应
宿主/亚型
分类
类型
抗原
偶联物
形式
浓度
规格
纯化类型
保存液
内含物
保存条件
运输条件
RRID
产品详细信息
Percent identity with other species by BLAST analysis: Human (100%) Gorilla, Gibbon, Monkey (94%) Marmoset (83%).
靶标信息
Putative taste receptor. TAS1R1/TAS1R3 responds to the umami taste stimulus (the taste of monosodium glutamate) and also to most of the 20 standard L-amino acids, but not to their D-enantiomers or other compounds. Sequence differences within and between species can significantly influence the selectivity and specificity of taste responses. Expressed strongly only in fungiform papillae.
仅用于科研。不用于诊断过程。未经明确授权不得转售。
篇参考文献 (0)
生物信息学
蛋白别名: G-protein coupled receptor 70; GPCR-B3; GPCRB3; seven transmembrane helix receptor; Taste receptor type 1 member 1; taste receptor, type 1, member 1; TS1R1; unnamed protein product
基因别名: GM148; GPR70; T1R1; TAS1R1; TR1
UniProt ID: (Human) Q7RTX1
Entrez Gene ID: (Human) 80835